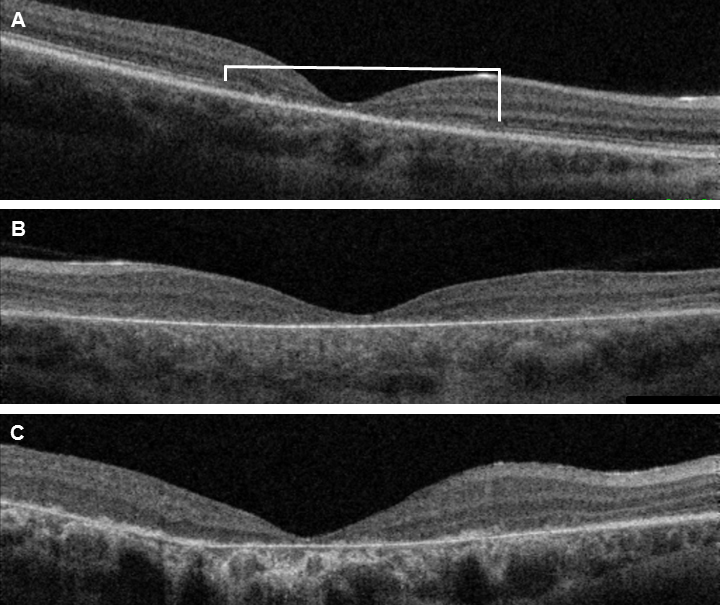

Figure 4. OCT images of one representative patient from each group. A: Loss of the photoreceptor integrity line (PIL; indicated by the white brace) in the macular region in patient 10 from group
1. The PIL corresponds to the junction of the inner and outer segments of the photoreceptors. The same pattern was encountered
in all but two patients in group 1. One of those two patients showed more extensive PIL loss, and the other had better preserved
but disorganized PIL. B: Representative total PIL loss and RPE atrophy in patient 24 from group 2. All but one patient in group 2 showed the same
optical coherence tomography (OCT) changes. Patient 19 had a defect PIL in the center but a preserved PIL beyond this. C: Patient 30 from group 3 also shows total PIL loss and extensive RPE atrophy as observed in the other patients in group 3.